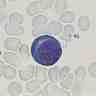
Érythroblaste Érythroblaste

hématie

Cellule sanguine (→ sang) transportant l'oxygène des poumons vers les tissus. (Synonymes : globule rouge, érythrocyte.)
1. Caractéristiques des hématies
L'hématie peut être considérée comme un sac transportant de l'hémoglobine, pigment protéinique de couleur rouge chargé de transporter l'oxygène.
1.1. Morphologie et composition des hématies

L'hématie, appelée aussi érythrocyte ou, dans le langage courant, globule rouge, a la forme d'un disque biconcave (disposée sur une lame de microscope, elle est circulaire) ; son diamètre est de 7 à 8 μm. C’est une cellule qui présente la particularité de ne pas avoir de noyau (cellule anucléée) ni d’organites cellulaires ; elle est constituée d'eau, d'ions (surtout potassium) et d'hémoglobine, protéine lui donnant sa couleur rouge. Chaque hématie peut renfermer 280 millions de molécules d'hémoglobine.

L'hématie se déforme facilement et peut ainsi voyager dans les plus petits vaisseaux sanguins, les capillaires, dont le diamètre est bien inférieur au sien, n’excédant pas 1 μm.
La membrane de l'hématie est faite de lipides, de protéines et d'une couche externe de mucopolysaccharides, qui comprend les antigènes définissant des groupes sanguins.
1.2. Cycle de vie des hématies


Les hématies sont produites par les érythroblastes (→ érythropoïèse), cellules souches de la moelle des os, dont elles représentent la dernière étape de différenciation. Ces érythroblastes expulsent leur noyau pour devenir des réticulocytes de globules rouges jeunes qui conservent pendant 48 heures environ des restes filamenteux.

La durée de vie des hématies humaines est en moyenne de 120 jours – à titre comparatif, elle est de 40 jours chez la souris et de 225 jours chez le lama. Au cours du vieillissement érythrocytaire, certaines enzymes perdent progressivement leur activité, tandis que les processus métaboliques, qui en dépendent, diminuent (→ métabolisme). Les hématies sont donc régulièrement renouvelées.
Au terme de leur vie, les hématies sont détruites dans la moelle osseuse et dans le foie, ainsi que, dans une moindre mesure, dans la rate. Cette destruction, appelée hémolyse, est effectuée par des macrophages. Les différents éléments constitutifs des hématies sont réutilisés par les cellules. Seule l'hémoglobine, riche en fer, suit un cycle particulier ; sa structure centrale, l'hème, est transformée sous l'action d'enzymes et libérée dans le plasma sous forme de bilirubine (pigment jaune-brun). Celle-ci passe ensuite dans la bile et est éliminée dans les fèces. Le fer est, lui, remis en circulation et réutilisé.
2. Fonction des hématies

Les hématies jouent un rôle fondamental dans la respiration en assurant le transport des gaz respiratoires (oxygène et dioxyde de carbone) entre les poumons et les tissus, grâce à l'hémoglobine qu’elles renferment. L'hémoglobine, qui a une très forte affinité pour l’oxygène, permet le transport d'une quantité d'oxygène 100 fois supérieure à celle acheminée par le plasma seul. (→ hémoglobine.)
3. Pathologies liées aux hématies
Chacun des éléments de l'hématie peut être l'objet de modifications constitutionnelles ou acquises : ainsi, il existe des anomalies des lipides ou des protéines de sa membrane, de l'hémoglobine, des enzymes. Certaines modifications n'ont pas de conséquences sur la vie du globule rouge ; d'autres affectent son espérance de vie et sont responsables d'anémies hémolytiques.
Dans l’anémie falciforme, ou drépanocytose, les hématies n’ont plus la forme d’un disque mais celle d’une faucille.
C’est dans les hématies que se multiplie le parasite responsable du paludisme.